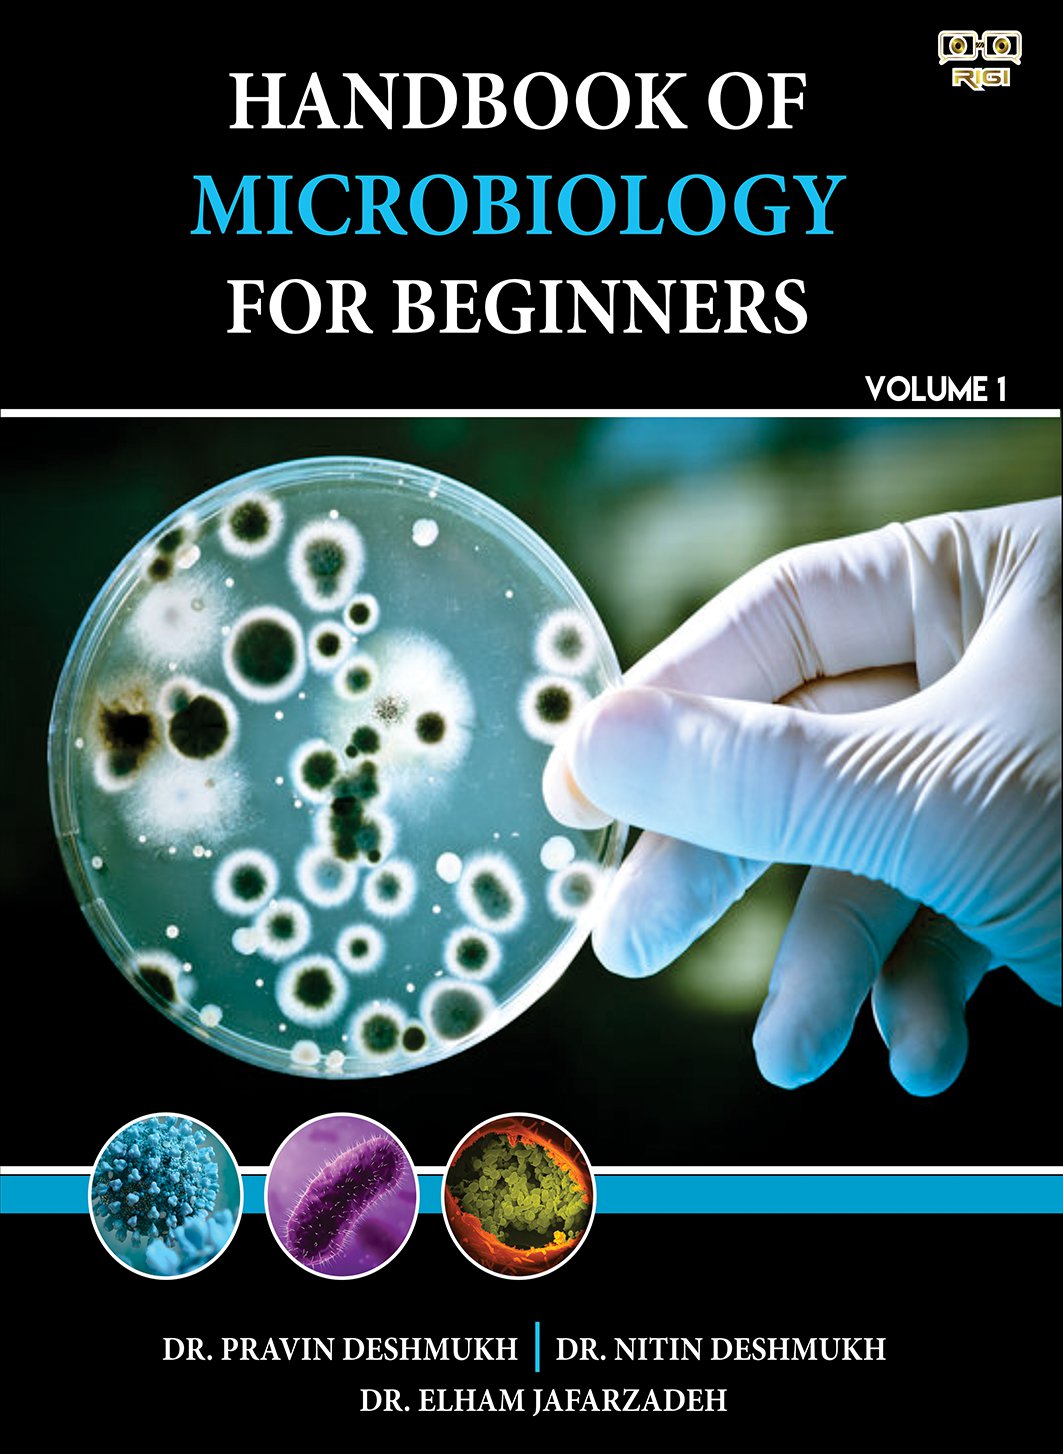
product image

Product Information
The aim of introducing “Handbook of Microbiology for Beginners” book is to provide updated experimental learning through active participation and doubtless concept clearance, which enables the student to develop and demonstrate analytical, judgmental, presentation and communication skills. This book will expose students to various common class tested experiments with emphasis on experimental components and specified learning outcomes in fields of microbiology that help students to understand the role of microorganisms in nature and students shall inspire for pursuing higher studies in microbiology. Furthermore this laboratory manual encourages students not only to gain knowledge of the laboratory safety but also to practice safety techniques. Additionally, this book will also enable and encourage students to get employed in the biological research institute, industries, and educational institutes concerning departments based on microbiology subject.
“Handbook of Microbiology for Beginners” contains 28 exercise designed to promote laboratory skills such as: Design of hypothesis, Follow experimental protocol, Collect and organize data, Draw appropriate conclusion based on results, effective management of time and task, etc.
Keypoints:
- Step-by-step experimental procedures
- Clear learning outcomes
- Emphasis on safety protocols
- Practical application of microbiological concepts
- Engaging and interactive exercises
Bullets:
- 28 hands-on exercises
- Emphasis on experimental skills
- Focus on laboratory safety
- Encourages analytical thinking
- Promotes effective time management
Information
| Format | , EBook |
|---|---|
| ISBN No. | 9789395773638 |
| Publication date | 20 October 2023 |
| Publisher | Rigi Publication |
| Publication City/Country: | India |
| Language | English |
| Book Pages | 156 |
| Book Size | 8.5" x 11.0" |
| Book Interior | Color interior with white paper |
About Author
Dr. Pravin Deshmukh, Dr. Nitin Deshmukh, and Dr. Elham Jafarzadeh are esteemed experts in the field of microbiology, bringing years of experience and expertise to this handbook. Their collective knowledge and dedication to education ensure that this book offers comprehensive and practical insights into microbiological principles and laboratory techniques.